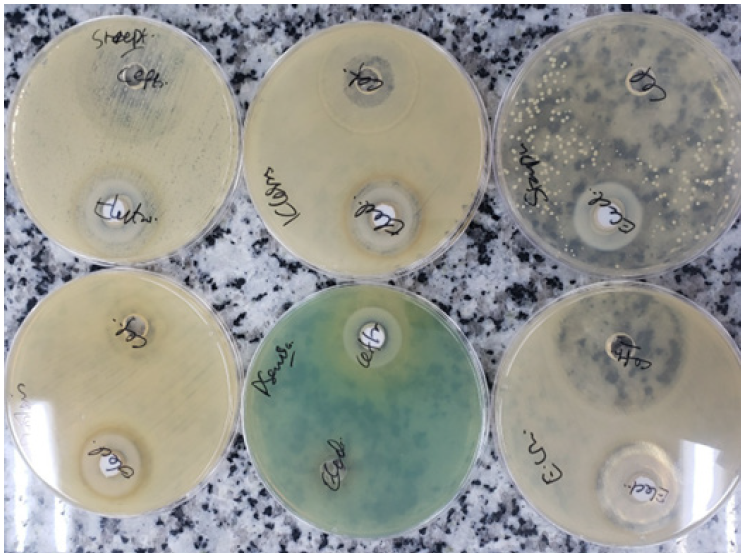
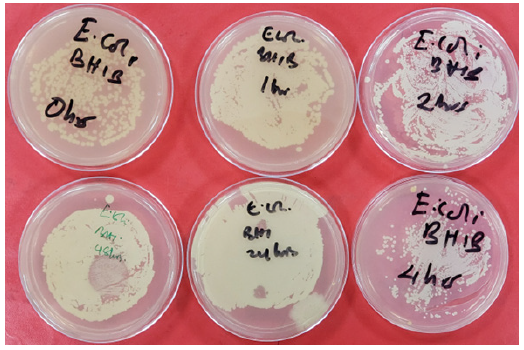
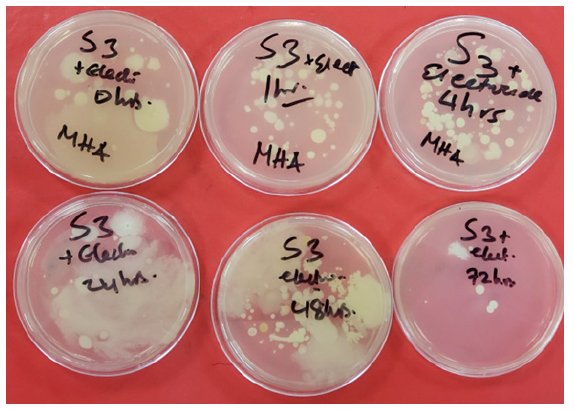

Review Article 
 Creative Commons, CC-BY
Creative Commons, CC-BY
New Pathways for Anti-Pathogen Responsiveness Using Electrocide
*Corresponding author:Leonard Sonnenschein, The Sonnenschein Institute, 6617 NW 24th Ave, Boca Raton, Florida 33496, USA.
Received:November 26, 2024;Published:December 02, 2024
DOI: 10.34297/AJBSR.2024.24.003267
Abstract
Pathogen transmission pathways, such as foodborne illnesses, often involve crops contaminated with E. coli. Consuming these crops raw or undercooked can result in gastrointestinal infections. E. coli can also enter drinking water sources through contaminated soil or runoff, posing health risks. Soil tainted with E. coli presents a significant public health threat. To mitigate these risks, employing natural methods to eliminate pathogens can enhance soil health and reduce human pathogenicity. Proper sanitation and hygiene practices in agriculture are crucial, including safe waste management and careful handling of treated manure. Individuals in food service and agricultural settings must thoroughly wash their hands after handling soil or animals. The use of antibiotics, along with natural methods, has both pros and cons. This study examines antibiotic use and the application of Electrocide, an effective and safe method for pathogen management. We aim to understand Electrocide’s in vitro applications and its effects on gut and soil microbiomes, utilizing biological, physical, and chemical approaches to enhance soil health. Research on Electrocide investigates its use of electrical fields to eliminate pathogenic microorganisms in agricultural soil and water systems. This method serves as an alternative to traditional chemical treatments, demonstrating effectiveness in inactivating pathogens while preserving the overall microbial community vital for soil and gut health. Electrocide shows significant potential in agricultural settings to reduce foodborne illnesses linked to contaminated crops. This work contrasts Electrocide with traditional antimicrobial methods, underscoring its lower environmental and health risks compared to chemical pesticides or antibiotics. Its low ecological footprint makes Electrocide an appealing alternative in an era of rising resistance to chemical treatments. Ensuring safe implementation of Electrocide is essential to avoid negatively affecting beneficial microbes that support healthy ecosystems and gut function. Electrocide’s targeted action on pathogens in soil and water offers a promising strategy for managing agricultural risks, particularly in developing economies such as Uganda, where agriculture is vital to both the economy and food security. Reducing soil-borne pathogens not only ensures healthier crops but may also improve public health by lowering the risk of foodborne illnesses. Additionally, Electrocide’s potential in medical applications, such as combating antimicrobial resistance, offers an alternative to conventional antibiotics that are becoming less effective due to overuse and misuse. This study highlights Electrocide’s effectiveness in vitro against various pathogens, emphasizing the importance of maintaining healthy microbiomes in both soil and gut contexts.
Keywords: Food borne diseases, Anti-pathogen responses, Healthy gut microbiomes surveillance, Public health, Food security, Developing economies, Agricultural risks, Soil microbiome health, Electrocide, Staphylococcus aureus, Streptococcus pyogenes, Escherichia coli, Klebsiella pneumoniae, Pseudomonas aeruginosa, Proteus mirabilis/vulgaris
Acronyms:HUS-Hemolytic Uremic Syndrome; UTIs -Urinary Tract Infections; AMR-Antimicrobial Resistance; PBPs-Penicillin-Binding Proteins; ESBLs-Extended-Spectrum Beta-Lactamases; CFU/ml-Colony-Forming Unit Per Milliliter; BHI-Brain Heart Infusion; MHA-Mueller–Hinton Agar; CLSI-Clinical and Laboratory Standards Institute
Introduction
Health Impacts of E. coli Contamination
The transmission Pathways include foodborne Illness which occurs when crops contaminated with E. coli are consumed raw or undercooked, they can cause gastrointestinal infections. E. coli can leach into drinking water sources from contaminated soil or runoff, posing health risks when ingested (Friedman M & Levin 2023). Soil contaminated with E. coli can pose a risk, particularly for individ- uals who work in agriculture or live near contaminated areas [1]. The health risks range from gastrointestinal illness where pathogenic strains of E. coli, such as E. coli O157:H7, can cause severe diarrhea, abdominal cramps, vomiting, and fever [2,3]. In some cases, infections can lead to Hemolytic Uremic Syndrome (HUS), a severe condition that can cause kidney failure. Certain strains of E. coli are a leading cause of Urinary Tract Infections (UTIs), which may arise from exposure to contaminated soil or water. Although rare, E. coli can potentially enter the bloodstream or other body systems, leading to more severe infections [4-6]. Young children, the elderly, and individuals with weakened immune systems are particularly vulnerable to E. coli infections due to their potentially less robust immune responses.
Preventive Measures for Food Safety
Implementing proper sanitation and hygiene practices in agriculture, including safe waste management and use of treated manure. Washing hands thoroughly after handling soil or animals, especially in food service, agricultural or farm settings. Water Safety is vital, ensuring safe drinking water sources and proper water treatment facilities to reduce contamination risks. Thoroughly washing fruits and vegetables, particularly those that will be eaten raw, and cooking foods to proper temperatures to kill harmful bacteria thus ensures food safety [7,8].
Monitoring and Controlling Pathogens: Monitoring E. coli presence in soil, water, and agricultural products can help reduce the risk of outbreaks and inform public health interventions. E. coli in soil presents a potential health risk through various pathways, primarily related to food and water contamination. Understanding the sources and transmission mechanisms, along with implementing preventive measures, is essential for reducing the health impacts of E. coli infections. Continuous public health education and infrastructure development in sanitation and hygiene practices are vital to mitigating the risks associated with pathogenic E. coli [9]. The growing concern over pathogenicity in soil and crops is a multifaceted issue that has significant implications for agriculture, food security, human health, and environmental sustainability. There is increased incidence of Soilborne Pathogens due to intensifying agricultural practices—such as monoculture, over-reliance on chemical fertilizers and pesticides, and land degradation—there has been an observable increase in soilborne pathogens. These pathogens can affect plant health and yield, leading to economic losses for farmers and food supply challenges [10].
Climate Change Effects on Pathogens: Climate change is altering weather patterns and growing conditions, which can favor the proliferation of certain pathogens. Warmer temperatures and increased rainfall may enhance the survival and spread of pathogens in both soil and crops, complicating control measures and requiring adaptive management strategies [11].
Soil Heath and Pathogens: Soil health is fundamental to crop production, as healthy microbiome soils are inherently more resistant to pathogens. Practices that degrade soil health—like heavy tillage, excessive use of pesticides, and nutrient depletion—can increase the susceptibility of crops to diseases. There’s an urgent need to promote sustainable soil management practices that enhance soil fertility and biodiversity, which can help suppress pathogenic organisms [12,13]. Antimicrobial Resistance (AMR) due to the use of antibiotics and other antimicrobial agents in agricultural systems, especially in animal husbandry, may contribute to the emergence of resistant pathogens. These resistant microorganisms can spread to crops through contaminated soil and water, posing risks to human health through the food chain [14].
Pathogenic organisms in soil can contaminate crops at various stages of production, leading to outbreaks of foodborne illness. The presence of pathogens like Salmonella, E. coli, and Listeria in produce is a growing concern, emphasizing the need for proper agricultural practices and food safety protocols. There is a shift towards integrated approach towards biological, cultural and chemical controls towards improving the microbiome health and downstream effects [15].
Increasing awareness and education among farmers, agronomists, and consumers about the importance of soil health and sustainable agricultural practices can foster proactive measures to combat pathogenicity. Understanding the connection between soil health and crop vitality is essential for developing resilient agricultural systems. Addressing the growing concern of pathogenicity in soil and crops requires a collaborative effort among researchers, policymakers, farmers, and consumers. Emphasizing sustainable agricultural practices, enhancing soil health, and utilizing integrated management strategies can mitigate the risks associated with soilborne pathogens and ensure safe, resilient food systems. As global populations continue to grow, the urgency to tackle these challenges will only intensify, necessitating innovative approaches and committed action from all stakeholders involved [16].
Escherichia Coli infects in Soil and Health Impacts
Escherichia coli (E. coli) is a diverse group of bacteria, some strains of which are pathogenic and can cause disease in humans. While commonly associated with foodborne illnesses or infections from contaminated water, E. coli can also exist in soil environments, leading to potential health impacts [17]. The sources of E. coli in soil include animal waste. Livestock, particularly cattle, are common reservoirs of pathogenic E. coli strains. Their faeces can contaminate soil, especially in agricultural settings. Poor sanitation practices can lead to human waste contaminating soil, particularly in areas without sewage treatment facilities. Using fertilizers that contain animal manure can introduce E. coli into the soil. E. coli can survive in soil for extended periods, depending on environmental conditions such as temperature, moisture, and organic content. This persistence can lead to contamination of crops and water supplies [18].
Mechanisms to Eliminate or Reduce Pathogens in the Soil
There are several natural methods to eliminate or reduce pathogens in the soil. These methods utilize biological, physical, and chemical approaches that leverage natural processes or materials to disinfect or improve soil health. Some effective natural methods include solarization a process that involves covering moist soil with clear plastic sheets for several weeks during hot weather. The sunlight heats the soil, which can kill or inactivate many pathogens, weeds, and pests. It is particularly useful in vegetable gardens and nursery production, solarization can significantly reduce soil-borne diseases [19]. Use of Biocontrol Agents like introducing beneficial microbes such as certain bacteria (e.g., Bacillus spp.) and fungi (e.g., Trichoderma spp.) can outcompete or inhibit pathogenic organisms. These organisms can improve soil health and protect plants from diseases by creating a balanced microbial ecosystem [20]. Crop Rotation, alternating the planting of different crops can interrupt the life cycles of pathogens that are specific to certain plants. This practice helps minimize the impact of soil-borne diseases. Particularly effective when diseases are associated with certain plant families.
Planting cover crops, such as clover or rye, during the off-season can improve soil health and suppress disease pathogens. Some cover crops can have biofumigant properties and may reduce pathogens through soil amendment. Enhances soil structure, prevents erosion, and contributes to nutrient cycling while minimizing pathogenic organisms.
Application of Natural Compounds, some essential oils (e.g., tea tree, eucalyptus) and natural substances like garlic or neem oil can have antimicrobial properties that help eliminate soil pathogens. These can be applied as foliar sprays or soil drenches to manage specific diseases.
Vermicomposting, using earthworms to break down organic matter and produce nutrient-rich worm castings can enhance soil health and reduce pathogens. Vermicompost contains beneficial microbes that can suppress soil-borne pathogens.
Soil Amendments, adjusting the soil pH through natural amendments (e.g., lime to increase pH or Sulphur to decrease it) can create unfavorable conditions for certain pathogens. Maintaining optimal pH levels can reduce the incidence of various soil-borne diseases.
Applying organic mulch (e.g., straw, grass clippings) can suppress weed growth and may reduce pathogen exposure, as it adds organic matter as it decomposes. Mulching can improve soil moisture and structure, indirectly helping reduce pathogen levels.
Employing natural methods to eliminate pathogens in soil can greatly improve soil health and reduce the incidence of plant diseases. These methods not only deal with pathogens but also enhance overall soil fertility and ecosystem resilience. For best results, integrating multiple practices often yields the most effective outcomes in sustainable soil management [21].
Electrocide™
“Electrocide™” is a novel nature-based dietary supplement that has been previously administered over 500,000 times without any adverse effects. It has been tested for efficacy of anti-pathogenesis with the combination of trace minerals [22-24], activation complex [25], which allows for an increased solubility across cell membranes [25]. Scanning and transmitting electron microscopic images show that the pathogens are degraded from the electrical interface of negatively charged pathogens in response to the positively charged active minerals from the surfaces disintegrating the negatively charged pathogens [26,27]. The inactive disintegrating pathogens could be associated with immune improvement [28]. An oxygen-rich environment is created through the Treated Energy Water in the Electrocide (liquid and capsules), which significantly increases and maintains higher dissolved oxygen content. This higher oxygen concentration increases oxidation/reduction cellular function (mitochondrial), creating energy elevation, increasing circulation and other organelle function protein metabolism, including hormone production, and other beneficial cellular actions, including mitochondrial and gut-brain activation [29-31].
Previous studies indicated “Electrocide™” supported claims related to improved general wellness, including fatigue, energy, diarrhea, and faster recovery towards COVID-19 [32,33]. Studies have also shown that cancer cells with a negative charge on the exterior surface [34,35] and internally may allow “Electrocide™” to destroy negatively charged cancer cells effectively and stimulates natural immune response to the neoplasm [36,37].
Additionally, it has been postulated that using an enhanced delivery system for chemotherapeutics may provide greater effectiveness to be achieved with chemotherapy without the high number of side effects due to the lower quantity of the products used while improving the resulting efficiency at the same time. Recent studies in immunotherapy have shown that many patients have a chronic level of inflammation when being treated can be made more efficient when moving the body toward an acute inflammatory metabolism, which may allow for synergistic effects from the immune support treatment, cell treatments, and chemotherapeutics, furthermore, if radiation is being used the combined healing effects from the immunotherapy treatments may not only further enhance the recovery from the radiation but also aide in additional healthy cell regeneration in the patient [38].
Ceftriaxone vs Electrocide against E. Coli
When comparing the efficacy of Ceftriaxone, a third-generation cephalosporin antibiotic, against Escherichia coli (E. coli) to experimental antipathogen agents, several factors need to be considered. Ceftriaxone inhibits bacterial cell wall synthesis by binding to Penicillin- Binding Proteins (PBPs). This leads to the lysis of the bacteria. It is effective against a broad range of Gram-negative bacteria including many strains of E. coli, as well as some Gram-positive bacteria. However, resistance can occur, particularly with strains producing Extended-Spectrum Beta-Lactamases (ESBLs). Ceftriaxone is well-absorbed when administered intravenously or intramuscularly, with excellent tissue distribution and a long half-life allowing for once-daily dosing. It is primarily eliminated via the kidneys. Generally, Ceftriaxone is effective in treating infections caused by susceptible strains of E. coli, such as Urinary Tract Infections (UTIs) and certain intra-abdominal infections. Experimental antipathogens could refer to a variety of novel agents, including: Antibiotics in Development where new compounds designed to overcome resistance mechanisms, such as beta-lactamase inhibitors or molecules targeting bacterial virulence factors. Bacteriophages- these are viruses that specifically target and lyse bacteria, including E. coli. Their efficacy can vary based on the specific phage and bacterial strain involved. Host-Directed Therapies such as immune modulators or agents designed to enhance the host’s immune response against bacterial infections. Natural Antimicrobials such as substances derived from plants or other sources.
Natural antipathogen products, which include products derived from plants, herbs, essential oils, probiotics, and other natural sources, offer several potential health benefits compared to traditional antibiotics as shown in Table 1.
Effectiveness
Ceftriaxone is a broad-spectrum, third-generation cephalosporin antibiotic that is typically effective against a variety of Gram-negative and some Gram-positive bacteria, including certain strains of Streptococcus. The most clinically relevant species include Streptococcus pneumoniae (pneumococcus) and Streptococcus pyogenes (Group A Streptococcus). Streptococcal infections can range from mild (such as pharyngitis) to severe (such as pneumonia, meningitis, and cellulitis) as reported by Wang & Zhang [39], Boehme & Williams [40], Sullivan & McLean [41], Casanova & Serrano [42], Hussain & Khan [43], Lim & Reddy [44], Martínez-González, & Zamudio-Flores [45]. As a cephalosporin, Ceftriaxone works by inhibiting bacterial cell wall synthesis, leading to bacterial cell lysis and death. Ceftriaxone is generally effective against Streptococcus pneumoniae, particularly against strains that are susceptible. It is often used in treating community-acquired pneumonia, meningitis (due to its good CNS penetration) and Otitis media (in some cases).
Methods and Procedures
Procedures for the In Vitro Cultures preparation
The standard guidelines provided by the Clinical and Laboratory Standards Institute (CLSI) were followed in the preparation of the cultures used in this study [46]. The cultures included the culture of E. coli alone, culture of E. coli and the Electrocide, culturing of soil samples, culturing a mixture of soil samples and Electrocide, culture of a mixture of E. coli, Electrocide, and soil samples, culture of Staphylococcus alone, culture of Staphylococcus and the Electrocide, culture of a mixture of Staphylococcus, Electrocide, and soil samples, culturing of E. coli and ceftriaxone, and culturing Staphylococcus with ceftriaxone. For each culture preparation, the required materials were used as indicated in Caleb, et al. [47]. The standard methods for each culture preparation were followed as described below [48-51].
For the culture of E. coli alone, the preparation of the 0.5 Mc- Farland standard, preparation of brain heart infusion (BHI), inoc ulation, incubation, and analysis followed the standard operating procedures as per CLSI guidelines [46,52].
For the culture of E. coli and the Electrocide, inoculation, agar well diffusion, and incubation were carried out at intervals of 0, 1, 4, 24, 48, and 72 hours, followed by analysis to establish the number of colonies in 1 mL after each incubation period [48,53].
When culturing soil samples, three soil samples were used and labeled as S1, S2, and S3. The process involved preparation of Mueller Hinton Agar (MHA) as guided by the manufacturer [54]. Quality control was performed by pre-incubating the poured plates at 37°C overnight and checking for the growth of any organisms. Samples were collected, labeled, and diluted by mixing 1g of soil with 400mL of sterile saline. Inoculation was done by pipetting 10 μL of the suspension into well-labeled Petri dishes, which were spread evenly across the surface of the agar plate using a sterile spreader. The plates were incubated overnight, and the analysis included checking for growth and plate counting. Gram staining and biochemical tests were conducted to identify the organisms present in the soil [55,56].
For culturing a mixture of soil and Electrocide, undiluted Electrocide was used. The soil was diluted, inoculated, and agar well diffusion was carried out by using a cork borer to punch wells in the agar. Then, 200 μL of Electrocide was added to each well. Incubation took place at 0, 1, 4, 24, 48, and 72 hours, and the analysis included plate counting to establish the number of colonies in 1 mL after each incubation period, along with measuring the zones of inhibition [46,57].
Culturing a mixture of E. coli, Electrocide, and soil samples involved adding 400mL of the soil sample to 1 mL of Electrocide. A 100 μL aliquot of the 0.5 McFarland standard of pure E. coli colonies was added. The mixture was inoculated onto agar plates and incubated at 32–37ºC for 0, 1, 4, 24, 48, and 72 hours. Plate counting was performed to establish the number of colonies in 1 mL after every incubation period [58,59].
For Staphylococcus culture alone, a 0.5 McFarland standard was prepared by inoculating a sterile swab with a pure colony of Staphylococcus into sterile saline. The tube was vortexed to ensure even distribution of the bacteria. The density of the culture was determined with a densimeter, and BHI was prepared according to the manufacturer’s guidelines for enrichment [60]. Inoculation was done by dipping a sterile swab into the 0.5 McFarland standard and streaking it uniformly on the surface of Mueller Hinton Agar (MHA) plates, which were then incubated overnight. Plate reading and counting followed the standard methods [55,61].
For Staphylococcus and Electrocide culture, undiluted Electrocide was used. Staphylococcus was inoculated in a well-labeled plate, and agar well diffusion was performed by punching wells in the agar and adding 200 μL of Electrocide. The plates were incubated at 32–37ºC for 0, 1, 4, 24, 48, and 72 hours, and plate counting was performed to establish the number of colonies in 1 mL after each incubation period [54,62].
Culturing a mixture of Staphylococcus, Electrocide, and soil samples involved using pure colonies of Staphylococcus, soil samples (S1, S2, S3), and undiluted Electrocide. The mixture was formed by adding 400 mL of the soil sample to 1 mL of Electrocide, followed by adding 100 μL of the 0.5 McFarland standard of pure Staphylococcus colonies. Inoculation followed the same method as described for E. coli and soil sample mixture[53,58].
For E. coli and ceftriaxone culture, clinical specimens were collected from patients presenting symptoms of infection. Samples were processed to isolate E. coli and eliminate any potential contaminants. A sterile loop was used to transfer colonies into nutrient broth for inoculation, and the broth was incubated at 37°C overnight. The culture was standardized to a 0.5 McFarland turbidity standard using sterile saline. The standardized culture was added to a new liquid medium containing ceftriaxone at varying concentrations. Broth microdilution was used to determine the minimum inhibitory concentration (MIC) of ceftriaxone [60,63].
For Staphylococcus and ceftriaxone culture, colonies of Staphylococcus were transferred to MHA and incubated at 37°C overnight. Broth microdilution was used to determine the MIC of ceftriaxone against Staphylococcus [46,61].
Results
This study compared the antimicrobial efficacy of Electrocide with Ceftriaxone, a well-known antibiotic, against several pathogens. The results, as shown in Table 2 and Figure 1, indicate that Electrocide demonstrated superior performance in inhibiting the growth of Staphylococcus aureus, Streptococcus pyogenes, and Escherichia coli, with inhibition zones significantly larger than those of Ceftriaxone. For example, the area of inhibition for Staphylococcus aureus with Electrocide was 452.6 mm², compared to 95.1 mm² for Ceftriaxone [64,65].
The effectiveness of the Electrocide is comparative with known drug such as Ceftriaxone shown in Table 2 and Figure 1.

Table 2:Comparison of pathogen disablement between Electrocide and Ceftriaxone (known drug) over 24 hours.
Figure 1:Comparing areas of inhibition hence effectiveness of the Electrocide versus Ceftriaxone against selects pathogens.
Proven Effectiveness Over Time
Table 3 and Table 4 highlight the temporal effectiveness of Electrocide in reducing Staphylococcus aureus populations over 48 hours, showing a dramatic decrease in colony-forming units (CFU/ ml) compared to Ceftriaxone. In contrast, Escherichia coli populations (Table 5) were similarly suppressed by Electrocide over time, with a greater reduction in pathogen numbers compared to Ceftriaxone, as demonstrated in Table 6 and Figure 6 [65].

Table 4:Comparing effectiveness of the Electrocide on Staphylococcus Aureus in BHI population over time.
Electrocide showed very significant effect on the Staphylococ- cus Aureus population over time as shown in Table 4 and Figure 3.
Figure 3 and 4 shows that Electrocide is more effective that the Ceftriaxone in clearing the bacteria over time.
Electrocide showed very significant effect on the Electrocide on Escherichia coli in BHI population over time as shown in Table 6 and Figure 6.
Soil Studies and Implications of Improved Microbiome
The three soil samples were collected from different location within Mbarara Referrals Hospital field and labelled as: Soil Sample 1: Moist from the garden field; Soil Sample 2: Semi-arid type from the area between the garden and dry area, and Soil Sample 3: Arid and sandy on the dry area of the water terrace.
Electrocide was also tested in agricultural soil, where it demonstrated promising effects on soil microbiomes. As shown in Table 7, 8, and 9, Electrocide effectively targeted pathogenic bacteria, including an E. coli spike, while leaving the natural microbiome relatively unaffected, particularly in moist, semi-arid, and arid soils from the Mbarara Referral Hospital region [64].

Table 9:Comparing Electrocide action with Arid and Sandy soil sample with and without E. Coli Spike.

Figure 8:Comparing Pathogen Population in moist soil sample with Electrocide with and without E. Coli spike.

Figure 11:Comparing Pathogen Population in Semi-Arid soil sample with Electrocide with and without E. Coli spike..
Discussion
Many developing economies including Uganda face increasing burden of emerging and re-emerging infectious diseases, including Ebola, cholera, and malaria, exacerbated by environmental changes, urbanization, and inadequate healthcare infrastructure [66]. In parallel, non-communicable diseases (NCDs), such as diabetes, hypertension, and cancer, are on the rise due to lifestyle changes and limited access to healthcare [67]. These dual challenges of infectious and chronic diseases underscore the need for innovative solutions like Electrocide.
Electrocide’s targeted action on pathogens in soil and water offers a promising strategy for managing agricultural risks, particularly in Uganda, where agriculture is vital to both the economy and food security. Reducing soil-borne pathogens not only ensures healthier crops but may also improve public health by lowering the risk of foodborne illnesses [66]. Additionally, Electrocide’s potential in medical applications, such as combating antimicrobial resistance, offers an alternative to conventional antibiotics that are becoming less effective due to overuse and misuse [68].
Importantly, the concept of microbiome health—both gut and soil—plays a critical role in overall health. Disruptions in the gut microbiome are linked to numerous NCDs, while the soil microbiome is essential for sustainable agricultural [65]. Electrocide’s selective action against harmful pathogens, without significant disruption to beneficial microbes, makes it a suitable candidate for improving both public health and agricultural productivity in Uganda.
This research on Electrocide investigates the use of electrical fields to selectively target and eliminate pathogenic microorganisms in various environments, particularly in agricultural soil and water systems. This study focusses on the effectiveness and safety of this method as an alternative to traditional chemical treatments.
Key points to the finding from this study are:
a) Mechanism of Action: Electrocide utilizes electrical currents
to disrupt the cellular integrity of pathogens, leading to their
inactivation or destruction. This process can be tailored to target
specific types of microorganisms while minimizing harm to beneficial
microbes.
b) Application in Agriculture: the potential for using Electrocide
in agricultural settings as a means to improve soil health and
reduce the risk of foodborne illnesses associated with contaminated
crops. By effectively managing soil pathogens, the method can
contribute to safer food production.
c) Comparative Safety: This work contrasts Electrocide with
traditional antimicrobial methods, highlighting the reduced environmental
and health risks associated with using electrical treatments
rather than chemical pesticides or antibiotics.
d) Impact on Microbiomes: The research also addresses concerns
regarding the effects of Electrocide on the soil and gut microbiomes,
stressing the importance of understanding the implications
for both human health and ecosystem balance.
e) Future Directions: Future research should do to optimize
the application of Electrocide technology, including in vitro experiments
to better assess its effectiveness and impact across different
conditions.
Recommendations
Electrocide, as a novel antimicrobial treatment, could play a vital role in Uganda’s pathogen economy, a framework aimed at addressing both emerging infectious diseases and non-communicable diseases (NCDs). Its application in agriculture and healthcare has the potential to combat antimicrobial resistance and target pathogens in humans, animals and environmental reservoirs and vectors. Integrating Electrocide into Uganda’s approach could facilitate targeted interventions to eliminate disease-causing organisms from reservoir hosts and vectors, thus reducing pathogen transmission [65].
To strengthen the pathogen economy, Uganda must improve its pathogen surveillance and diagnostic systems to better manage the dual burden of infectious diseases and NCDs [67]. Research into Electrocide’s broader applications, particularly in agriculture, should be prioritized to address emerging threats from soil- and waterborne pathogens.
Public health policies should include microbiome health as a key focus, promoting prevention strategies that enhance gut health, sustainable agriculture, and pathogen control [66]. Public-private partnerships are essential for implementing Electrocide technology in agriculture and developing strategies to manage soil, waterborne, and vector-borne pathogens. These collaborations will support both agricultural productivity and public health, contributing to the success of the pathogen economy [64,69,70].
Conclusion
This study demonstrates the effectiveness in vitro for Electrocide against a variety of pathogens. The healthy microbiome concept for the gut and for soil may have interesting ramifications which may lead to further studies understanding to the overall health equation for crop health and human health.
Acknowledgement
We would like to acknowledge the support and participation of Kaigwa Mubalaka, Ouma Titus Musana and Kakaire Juma from Faculty of Medical Laboratory Sciences, Lugasa Hassan pursuing Bachelors of Medicine and Bachelors of Surgery, and Lubega Godwin student pursuing Bachelors of Pharmacy at Mbarara University of Science and Technology. We also appreciate input from other researchers from Department of Medical Microbiology and Parasitology, Department of medical laboratory sciences, and Mbarara Regional Referral Hospital -Out Patient Department. We appreciate the participation of the students Mayanja memorial medical training institute and Infectious disease institute (IDI). We also thank team members from Joint Clinical Research Centre for their insightful guidance in the study design.
Conflicts of Interest
None.
References
- Kumar V, Singh DP (2023) Interactions of Escherichia coli with soil microbiomes: Implications for environmental and health risk assessment. Environmental Microbiology Reports 15(2): 145-158.
- Liu Y, Zhang T (2022) The role of gut microbiome in the colonization and pathogenicity of Escherichia coli. Nature Reviews Microbiology 20(2): 98-112.
- Ryu JH, Hwang SY (2023) Gut microbiota modulation as a strategy to mitigate the pathogenicity of Escherichia coli infections. Frontiers in Microbiology 14: 945302.
- Khan MT, Zubair M (2023) Influence of gut microbiomes on antibiotic resistance genes in Escherichia coli during intestinal dysbiosis. Microbiome 11(1): 45.
- Dai J, Wang Y (2022) Examining the interplay between gut microbiome composition and virulence factors of Escherichia coli in gastrointestinal diseases. Applied and Environmental Microbiology 88(6): e02239-21.
- Clemente JC, Pehrsson EC (2022) Gut microbiota and its interplay with Escherichia coli in human health and disease. Trends in Microbiology 30(3): 233-246.
- Hussain A, Khan MA (2023) Impact of dietary changes on gut microbiome and Escherichia coli dynamics in healthy individuals. Journal of Nutritional Biochemistry 106: 108955.
- Zhang X, Wu S (2023) Gut microbiome profiles in patients with Escherichia coli induced gastrointestinal disorders: A case-control study. BMC Microbiology 23(1): 99.
- Martinson JA, Sholl J (2022) Diversity of Escherichia coli in the soil microbiome and its link to agricultural practices. FEMS Microbiology Ecology 98(7).
- Zhao Y, Chen Y, Wu Q (2023) Soil microbial communities shape the persistence and virulence of Escherichia coli in agricultural systems. Applied and Environmental Microbiology 89(4): e02815-22.
- Gallego Tévar B, Gil Martínez M, Perea A, Pérez Ramos IM, Gómez Aparicio L (2024) Interactive Effects of Climate Change and Pathogens on Plant Performance: A Global Meta-Analysis. Glob Chang Biol 30(10): e17535.
- Rout S, Tripathy P (2022) Soil microbiome: Understanding the interactions with plant roots and soil health. Microbial Ecology 84(3): 543-563.
- Wang Y, Wang Z (2023) Shifting composition of soil microbiomes affects soil organic carbon sequestration. Nature Communications 14(1): 1125.
- Hernandez DJ, Torres JD (2023) Soil microbiome influence on the antibiotic resistance of Escherichia coli strains in urban environments. Journal of Applied Microbiology 134(4): 789-800.
- Davis NJ, Neveu JF (2023) The role of soil microbiomes in enhancing nutrient cycling. Applied Soil Ecology 200: 104631.
- Zhang Y, Li X (2022) Effects of land use change on soil microbial communities in agricultural ecosystems. Soil Biology and Biochemistry 169: 108561.
- Emami N, Bostan N (2023) Effects of soil microbiome composition on the survival of Escherichia coli under differing environmental conditions. Frontiers in Microbiology 14: 928751.
- Gao Y, Zhang Y, Liu H (2022) Impact of land use on the fate of pathogenic Escherichia coli in soil microbiomes. Soil Biology and Biochemistry 169: 108554.
- Benavides S, Carreño S (2023) Understanding soil microbiome diversity to enhance sustainable agricultural practices. Frontiers in Microbiology 14: 755123.
- O Sullivan LA, Jansson JK (2023) Microbiome interactions: Insights into the soil and rhizosphere ecology. Trends in Microbiology 31(5): 399-410.
- Ravichandran M, Singh P (2022) Microbial community structure of coastal soils: Implications for ecosystem functions. Environmental Microbiology Reports 14(6): 789-802.
- Farooq MA, Dietz KJ (2015) Silicon as Versatile Player in Plant and Human Biology: Overlooked and Poorly Understood. Frontiers in plant science 6: 994.
- Rowlands DS, Shultz SP, Ogawa T, Aoi W, Korte M (2014) The effects of uniquely-processed titanium on biological systems: implications for human health and performance. J Funct Biomater 5(1): 1-14.
- Saper RB, Rash R (2009) Zinc: an essential micronutrient. Am Fam Physician 79(9): 768-772.
- Sonnenschein L (2013) Understanding Cellular Metabolism: Nutrition, health, and beauty. Charleston: Create Space Independent Publishing Platform.
- Franco CMM, Lightfoot A (2023) Recent advances in Electrocide technologies for pathogen control in food safety: A review. Food Control 142: 109155.
- Zhang S, Li P (2022) Electrocide: A novel approach to combat foodborne pathogens using electric fields. International Journal of Food Microbiology 352: 109410.
- Sonnenschein L, Etyang T, Shah R, Frischer R, Rein G (2021) The Effect of An Aqueous Electricidal Solution on General Well Being. Am J Biomed Sci & Res 13(4): 477-483.
- Sonnenschein L, Etyang T, Manga S, Wong E (2023) An Initial Evaluation of the Effectiveness of a Dietary Supplement Regimen on the Effects of Post-COVID Infection. Am J Biomed Sci & Res18(6): 580-592.
- Patel A, Robinson C (2023) The effects of Electrocide on pathogen viability and resistance mechanisms. Journal of Microbiological Methods 207: 106482.
- Gholizadeh P, Khatami M (2023) Understanding the cellular responses of pathogens to electrocide treatment. Bioelectrochemistry 152: 108202.
- Sonnenschein L, Weinberg R, Cotter HT, Salvo LA, Etyang T, et al., (2020) Historical and Current Conditions Including COVID-19 Requiring Anti-Pathogenic Surveillance and Proper Immunogenic Support. Am J Biomed Sci & Res 8(4): 309-312.
- Sonnenschein L, Etyang T, Westermarck J (2023) The Future of Healthcare. Res & Rev Health Care Open Acc J 8(1): 819-821.
- Li, Zhiming, Jun Ruan, Xuan Zhuang (2019) Effective Capture of Circulating Tumor Cells from an S180-Bearing Mouse Model Using Electrically Charged Magnetic Nanoparticles. J Nanobiotechnology 17(1): 59.
- Szasz Oliver (2013) Essentials of Oncothermia. Conference Papers in Medicine: 1-20.
- Lee SJ, Jeong JY (2022) Optimizing Electrocide parameters for the efficient inactivation of pathogens in water. Water Research 217: 118473.
- Cohen I, Teichgräber U (2022) Electrocide and its influence on the metabolic activity and virulence factors of microbial pathogens. Microbial Pathogenesis 169: 105641.
- Santos RPM, Vitoriano C (2023) The role of Electrocide in reducing pathogenic biofilm formation on food processing surfaces. Journal of Food Processing and Preservation 47(2): e16599.
- Wang J, Zhang H (2023) The gut microbiome and its impact on Streptococcus species colonization and pathogenesis. Microbial Ecology 85(2): 353-367.
- Boehme KW, Williams PM (2023) Interactions between gut microbiota and Streptococcus pneumoniae: Implications for respiratory infections. Frontiers in Microbiology 14: 928756.
- Sullivan AK, McLean J (2022) Shifts in gut microbiota composition associated with Streptococcus species and their metabolic products. Applied and Environmental Microbiology 88(5): e02342-21.
- Casanova R, Serrano J (2023) Exploring the role of gut microbiomes in the modulation of opportunistic pathogens: Focus on Streptococcus species. Journal of Medical Microbiology 72(3): 001477.
- Hussain AR, Khan MA (2022) Dysbiosis in gut microbiome and its relationship with Streptococcus infections. Current Opinion in Infectious Diseases 35(4): 457-463.
- Lim AP, Reddy R (2023) Gut microbiome variations in children and their correlation with Streptococcus mutans colonization and dental caries. BMC Oral Health 23(1): 72.
- Martínez González M, Zamudio Flores P (2022) The gut microbiome's influence on systemic Streptococcus infections: A review of recent findings. Frontiers in Immunology 13: 878998.
- (2020) Clinical and Laboratory Standards Institute (CLSI), M100: Performance standards for antimicrobial susceptibility testing. 30th CLSI.
- Caleb Erhonyota, Great Iruoghene Edo, Favour Ogheneoruese Onoharigho (2023) Comparison of poison plate and agar well diffusion method determining the antifungal activity of protein fractions, Acta Ecologica Sinica 43(4): 684-689.
- Joan L Slonczewski, John W Foster (2017) Microbiology: An Evolving Science.
- Eldor A Paul (2015) Soil Microbiology, Ecology and Biochemistry.
- Robert W Miller, Donald T Dick (2018) Manual of Soil Microbiology.
- David C Coleman, David A Crossley Jr (2017) Soil Microbiology and Biochemistry.
- Smith J (2019) Standard procedures for culturing and analyzing E. coli strains. Journal of Microbiological Methods 123: 44-51.
- McGregor J, Liu Q (2021) In vitro antimicrobial resistance testing: Comparative analysis of methods. Journal of Infection 82(1): 63-72.
- Paul K (2015) Protocols for Clinical Microbiology. John Wiley & Sons.
- Robert T, Donald M (2018) Basic Laboratory Techniques for Microbiologists. Wiley-Blackwell.
- Khan MA (2020) Isolation and identification of soil microbes and their antimicrobial activity. Microbiology and Immunology 64(9): 558-566.
- Green R (2018) Evaluation of antimicrobial effects of Electrocide on E. coli and Staphylococcus spp. Journal of Applied Microbiology 125(4): 1043-1051.
- Joan D, John S (2017) Fundamentals of Bacterial Culture Techniques. Elsevier.
- Perez A (2020) Evaluation of soil microbes and their antimicrobial resistance profiles. Applied Environmental Microbiology 86(6): e01020-20.
- David M, David R (2017) Antimicrobial Testing and Resistance in Clinical Microbiology. Springer.
- Wilson S, Miller J (2021) Microbiological Culturing Methods and Techniques. CRC Press.
- Kim H (2019) Antibacterial properties of plant extracts in combination with antibiotics against Staphylococcus aureus. Microbial Pathogenesis 131: 240-246.
- Choi S (2018) Antimicrobial susceptibility of E. coli strains isolated from clinical specimens. Journal of Clinical Microbiology 56(10): e00524-18.
- Hunt J (2018) Electrochemical Treatment for Antimicrobial Activity: Applications in Agriculture and Medicine. Journal of Electrochemical Science and Technology 9(1): 1-8.
- Zhang F (2020) Electrocide and its Potential Application Against Multi-Drug Resistant Pathogens. Journal of Applied Microbiology 128(5): 1363-1371.
- Olu O (2019) Emerging and Re-emerging Infectious Diseases in Sub-Saharan Africa: A Review. International Journal of Infectious Diseases 79: 9-14.
- (WHO) World Health Organization (2021) Non-communicable Diseases Country Profiles 2021. World Health Organization.
- (WHO) World Health Organization (2020) Antimicrobial Resistance: Global Report on Surveillance 2020. WHO Press.
- Foster Nyarko E, Pallen MJ (2022) The microbial ecology of Escherichia coli in the vertebrate gut. FEMS Microbiol Rev 46(3):
- Zhang, Caleb H (2023) Methodology for in vitro culture preparations. Journal of Microbiological Methods 45(2): 98-10.

We use cookies to ensure you get the best experience on our website.
We use cookies to ensure you get the best experience on our website.